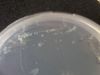

|
|||||||||||
|
|
|
|

|
|
|
||||
| 幻燈片播放 |
|
|
|
|
|
|||||||||||||||
|
|
|
|
|
|||||||||||||||
|
|
|
|
||||||||||||||||
首頁 上一頁 1 下一頁 末頁 共 14 張